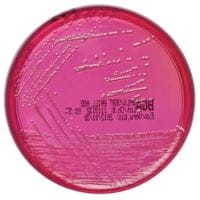
Brilliant Green Agar (Modified) gotowa pożywka do identyfikacji Salmonelli

Ezy 10 ul sterylne, sterylizowane radiacyjnie, czerwone
•Rozmiar: 10ul
•Sterylne: Sterylizowane radiacyjnie
•Kolor: Czerwony
•Ilość W opakowaniu: 1000 szt.
•Pakowane: Po 20 szt. opakowanie strunowe
•Wyrób medyczny: Tak
 Opis
Opis
Precyzyjne i niezawodne ezy do laboratoriów mikrobiologicznych
Pętle inokulacyjne MICROLOOPS® MWE to profesjonalne narzędzia przeznaczone do precyzyjnej techniki wolumetrycznej. Zaprojektowane z myślą o dokładności i niezawodności, są idealnym wyborem dla laboratoriów mikrobiologicznych oraz medycznych.
- Pojemność: 10 μl – precyzyjne przenoszenie próbek.
- Sterylizacja: Radiacyjna – zapewnia bezpieczeństwo użytkowania w badaniach mikrobiologicznych.
- Pakowanie: 1000 szt. w poręcznych woreczkach strunowych po 20 szt., co ułatwia przechowywanie i użytkowanie.
Kluczowe cechy produktu
Dokładność i niezawodność
MICROLOOPS® MWE posiadają certyfikat kalibracji, który potwierdza precyzję objętościową każdej pętli. Gładkie krawędzie chronią powierzchnię agaru przed uszkodzeniem, zapewniając bezpieczeństwo i niezawodność przenoszenia próbek.
Sterylizacja radiacyjna
Każda pętla jest sterylizowana radiacyjnie, co gwarantuje gotowość do bezpiecznego użycia oraz spełnienie wymagań higienicznych w badaniach mikrobiologicznych.
Zgodność z normami
Pętle MICROLOOPS® są oznaczone znakiem CE i spełniają standardy ISO, co jest gwarancją najwyższej jakości i bezpieczeństwa.
Zastosowanie
Pętle inokulacyjne MICROLOOPS® MWE są idealne do zastosowań w:
- Laboratoriach mikrobiologicznych: Przenoszenie próbek płynnych oraz praca z podłożami agarowymi.
- Placówkach medycznych: Precyzyjne przenoszenie materiału biologicznego.
- Przemysłowych badaniach jakościowych: Doskonała zwilżalność i elastyczny trzon zapewniają efektywną pracę.
Wybierz MICROLOOPS® MWE
Zapewnij sobie niezawodność i precyzję w każdym badaniu mikrobiologicznym dzięki pętlom inokulacyjnym MICROLOOPS® MWE.
__________________________________________________________________________________________________________________________________________________________________________________________
Jest to wyrób medyczny.
Wyrób medyczny przeznaczony wyłącznie do użytku profesjonalnego, zgodnie z definicją zawartą w art. 2 pkt 1.26 Ustawy o wyrobach medycznych. Produkty te nie są przeznaczone do stosowania w warunkach domowych. Zakupu mogą dokonać jedynie osoby posiadające Prawo Wykonywania Zawodu (PWZ) lub firmy, podając numer NIP podczas składania zamówienia. W przypadku zamówienia złożonego przez użytkownika domowego, zostanie ono anulowane, a ewentualna wpłata zwrócona na konto klienta.
__________________________________________________________________________________________________________________________________________________________________________________________
 Koszty dostawy
Cena netto, nie zawiera podatku
Koszty dostawy
Cena netto, nie zawiera podatku
darmowa i wygodna wysyłka
już od 800 zł netto
Najwyższa jakość
produktów potwierdzona certyfikatami
Zakupy 24h na dobę
wygodne i bezpieczne
bezpłatna konsultacja
z ekspertem online